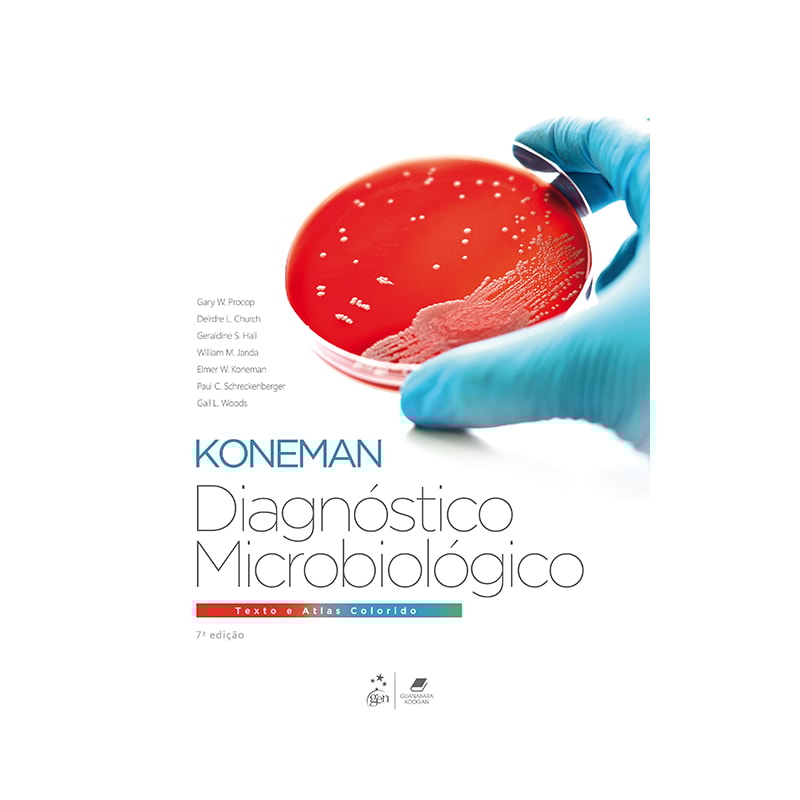
DIAGNÓSTICO MICROBIOLÓGICO - TEXTO E ATLAS COLORIDO

Bem vindo(a) à Livraria Loyola!
- Livros
- RELIGIÃO E ESPIRITUALIDADE
- LIVROS IMPORTADOS
-
Objetos Liturgicos
-
PAROQUIAIS
- Âmbula e Cibório
- Anel Episcopal
- Apagador de Vela
- Asperge
- Bandeja para Comunhão
- Base para Haste
- Caldeira
- Cálice
- Candelabro
- Castiçal e Porta Círio
- Círio Pascal
- Concha Batismal
- Conjunto Duas Espécies
- Coroa Advento
- Cruz Peitoral
- Cruz Processional
- Estante de Altar
- Fluído
- Galheta
- Hóstia e Vinho
- Incenso e Carvão
- Jarra e Bacia
- Lâmpada do Santíssimo
- Lanterna e Toucheiro Processional
- Mala de Missa e Estojo
- Ostensório
- Patena
- Pia Batismal
- Pinça Eucarística
- Purificador
- Redoma
- Relicário
- Sacrário
- Santos Óleos
- Sineta e Carrilho
- Sineta e Carrilho
- Suporte de Ostensório
- Teca e Caixa para Hóstia
- Turíbulo e Naveta
- Velas
- Via Sacra
- PARAMENTOS
-
PAROQUIAIS
-
Imagens Devocionais
- ANJO
- JESUS CRISTO
- NATAL
-
NOSSA SENHORA
- Imaculado Coração de Maria
- Maria Passa na Frente
- Nossa Senhora Aparecida
- Nossa Senhora Auxiliadora
- Nossa Senhora da Assunção
- Nossa Senhora da Caridade
- Nossa Senhora da Divina Providência
- Nossa Senhora da Oferta
- Nossa Senhora da Saúde
- Nossa Senhora das Dores
- Nossa Senhora das Graças
- Nossa Senhora das Lágrimas
- Nossa Senhora das Mercês
- Nossa Senhora de Fátima
- Nossa Senhora de Guadalupe
- Nossa Senhora de La Salette
- Nossa Senhora de Lourdes
- Nossa Senhora de Medjugorje
- Nossa Senhora de Nazaré
- Nossa Senhora de Pietá
- Nossa Senhora Desatadora dos Nós
- Nossa Senhora do Carmo
- Nossa Senhora do Desterro
- Nossa Senhora do Perpétuo Socorro
- Nossa Senhora do Rosário
- Nossa Senhora dos Anjos
- Nossa Senhora dos Milagres
- Nossa Senhora Grávida
- Nossa Senhora Imaculada Conceição
- Nossa Senhora da Rosa Mística
- PAPA
- SANTAS
-
SANTOS
- Frei Damião
- Santo Antõnio
- Santo Expedito
- Santo Ivo
- Santo Onofre
- Santo Padre Cicero
- São Benedito
- São Bento
- São Caetano
- São Charbel Makholuf
- São Cosme e Damião
- São Cristovão
- São Dimas
- São Francisco de Assis
- São Francisco de Paula
- São Geraldo
- São João Batista
- São João Bosco
- São João Paulo II
- São Joaquim
- São Jorge
- São José
- São Judas
- São Longuinho
- Santo Padre Pio
- São Paulo
- São Pedro
- São Sebastião
- São Tarcísio
- LEMBRANÇAS
- Devocionais
- Papelaria
- Colégios 2026